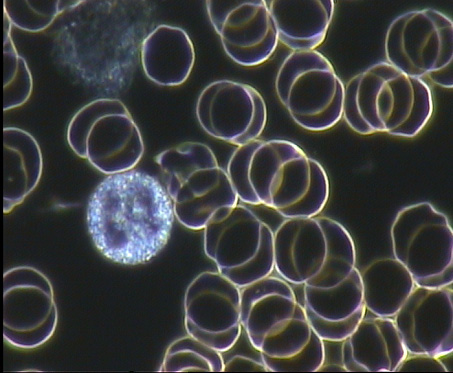
Abb.6

|
Hohe Lichtintensität
|
Eine 100 W Halogenlampe
liefert die für die Dunkelfeldmikroskopie bei höchsten
Vergrößerungen notwendige Lichtintensität.
|
|
Keine Erwärmung des Präparates
|
Halogenlampen strahlen
sehr viel Wärme ab. Um sie von dem Präparat fernzuhalten,
wird das Licht zunächst durch ein Wärmeschutzfilter geführt
und dann in einen Lichtleiter eingekoppelt, der keine Wärme
durchlässt.
|
|
Spezieller Dunkelfeldkondensor
|
Darstellungen
im Dunkelfeld bei stärksten Vergrößerungen erfordern
spezielle Kondensoren. Sie entscheiden in hohem Maße über
die Qualität des mikroskopischen Bildes. Der von Hund
eingesetzte Dunkelfeldkondensor ist ein Kardioid-Kondensor, der
höchste Aperturen garantiert und damit optimalen Kontrast und
höchste Auflösung.
|
|
Spezielles Dunkelfeldobjektiv mit Irisblende
|
Ein hochwertiges
SPL-Objektiv mit Irisblende erlaubt eine optimale Einstellung des
Dunkelfeldes, so dass auch feinste Strukturen im Präparat
sichtbar gemacht werden können.
|
|
Anschlußmöglichkeiten für Videoeinrichtungen bzw. Digitalkameras
|
Zur Demonstration /
Dokumentation des mikroskopischen Bildes stehen verschiedene Tuben
und Adapter zur Verfügung.
|
|
Speicherung / Archivierung / quantitative Auswertung der Dunkelfeldbilder
|
Hund bietet
Anschlussmöglichkeiten zur Speicherung des Bildes in einem PC
oder Notebook und Software zur quantitativen Auswertung der Bilder.
|